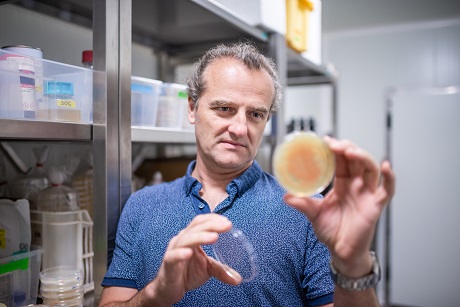

Jak buňky reagují na stres? Tým zpřesnil popis vzniku protistresového proteinu
26. 03. 2024
V případě nedostatku kyslíku nebo živin zažívají buňky stres. Protein ATF4 jim pomáhá stres zvládnout. Pokud neuspěje, mohou se buňky začít nekontrolovaně dělit a způsobit nádorové onemocnění. Molekulární mechanismus, jímž buňka protistresový protein vytváří, je známý již delší dobu. Nyní se ale vědcům z Mikrobiologického ústavu AV ČR podařilo popsat novou, komplexnější cestu jeho vzniku. Výsledky, které publikoval časopis Cell Reports, jsou klíčové pro pochopení, jak naše těla reagují na stres. Mohou tak v budoucnu přispět k výzkumu léčby závažných onemocnění.
Buňky si vyvinuly různé mechanismy, kterými reagují na stresové situace. Příkladem jsou signální dráhy, které po aktivaci cíleně ovlivňují a mění chování buňky. Právě ATF4 protein je klíčovým průsečíkem několika takových signálních drah, který udává, co se stane se stresovanou buňkou hned v několika ohledech.
„Tento protein umožní buňce v okamžiku úplně přeprogramovat její činnost, aby všeho nechala a veškerou energii soustředila na vyrovnání se s daným stresem. Pokud se jí to v přesně daném časovém okamžiku nepodaří, ATF4 spustí programovanou buněčnou smrt, aby se takto stresovaná buňka nestala pro své okolí nebezpečnou – například zhoubnou, tedy nekontrolovaně se dělící,“ vysvětluje Anna Michajlovna Smirnova z Laboratoře regulace genové exprese v Mikrobiologickém ústavu AV ČR.

Laboratoř regulace genové exprese vznikla v roce 2006 a zabývá se výzkumem syntézy proteinů a její regulací.
Zpřesnění popisu
Mechanismus, jímž buňka ve stresových situacích protein ATF4 syntetizuje, popsaly ve dvou prestižních publikacích už v roce 2004 hned dvě vědecké skupiny – tým Ronalda Weka v Indiana University School of Medicine a tým Davida Rona v University of Cambridge.
„Dlouho se pak mělo za to, že tato mnoho let trvající záhada byla jednou pro vždy vyřešena. Časem se ale začaly hromadit výsledky jiných studií, které naznačovaly, že molekulární mechanismus regulace syntézy tohoto důležitého bojovníka proti stresu je mnohem složitější, než se původně zdálo,“ říká vedoucí pražské laboratoře Leoš Shivaya Valášek.
Jeho tým se proteinem ATF4 zabývá posledních zhruba deset let. „Zatímco během stresové situace se syntéza velké většiny proteinů v buňce prakticky zastaví, syntéza ATF4 se naopak rozjede na plno. Děje se tak díky speciálním regulačním prvkům, které se nacházejí na začátku mRNA, jež tento protein kóduje,“ vysvětluje vědec.

Schéma pochází ze studie, uveřejněné v Cell Reports. Vedle vědců z laboratoře regulace genové exprese se na ní podíleli výzkumníci z Varšavské univerzity, Univerzity v New Yorku nebo Case Western Reserve University v Clevelandu.
Špičkový základní výzkum
Objev je důležitý při zkoumání nových léčebných terapií. „Vzhledem k tomu, že deregulovaná syntéza ATF4 provází různé patologické stavy, včetně nádorových onemocnění, naše práce jasně ukazuje, že při zvažování vhodných terapií, které cílí na ATF4, je třeba brát na zřetel komplexnost kontroly syntézy tohoto klíčového regulátoru života či smrti stresovaných buněk,“ doplňuje Leoš Shivaya Valášek.
Laboratoř regulace genové exprese vznikla v roce 2006 a zabývá se studiem jednoho ze základních molekulárně-biologických procesů v buňce, tj. syntézou proteinů a její regulací jak na všeobecné, tak na genově specifické úrovni.
Leoš Shivaya Valášek obdržel v roce 2020 prestižní Akademickou prémii.
Převážně základní výzkum laboratoře se zaměřuje na poznání toho, jak buňka dokáže dešifrovat genetický kód DNA a přeložit – pomocí velmi složitého mechanismu – informaci z jednotlivých genů, coby „úložišť dat“, do proteinů, coby „vykonavatelů“ drtivé většiny buněčných funkcí. Vědce a vědkyně z této laboratoře taky zajímá, jak je dění regulováno v rámci stále se měnících podmínek, jimž je buňka vystavována a na něž musí rychle reagovat změnou repertoáru proteinů, které zrovna syntetizuje.
V březnu 2016 byla na doporučení mezinárodní hodnoticí komise laboratoř vybrána mezi 13 nejprestižnějších laboratoří z celé Akademie Věd ČR. V roce 2020 obdržel Leoš Shivaya Valášek nejvýznamnější ocenění AV ČR Akademickou prémii, která zajistila jeho týmu finanční podporu až 30 milionů korun na období šesti let.
O výzkumu laboratoře vedené Leošem Shivayou Valáškem jsme psali v časopise A / Věda a výzkum 4/2020, webová verze článku je dostupná rovněž pod názvem Oceněný mikrobiolog zkoumá, jak fungují buněčné procesy na webových stránkách Akademie věd.
O vědci jsme při příležitosti udělení Akademické prémie natočili videomedailonek:
Text: Leona Matušková, Divize vnějších vztahů SSČ AV ČR, s využitím tiskové zprávy AV ČR
Foto: Jana Plavec, Divize vnějších vztahů SSČ AV ČR, úvodní foto: archiv Mikrobiologického ústavu AV ČR
Přečtěte si také
- Reprodukční odysea aneb Jak chytit nejkvalitnější spermii
- Plísně jsou vděčné téma, nikoho nenechají chladným, říká mykolog
- Breberky mě fascinovaly odmala, říká mikrobiolog Michal Kraus
- Učíme se, vybavujeme si a zapomínáme. Co dokáže paměť a jak ji přelstít?
- Nádorové buňky jako zlodějky. Jak posílit imunitní systém, aby na ně vyzrál?
- Nová sloučenina chrání kostní buňky, může pomoci pacientům s cukrovkou
- Růst listů, kořenů, kvetení i rozmnožování aneb Za vším hledej hormon
- Řekni mi to vůní. Pachová komunikace řídí životy zvířat i lidí
- Luční kvítí klíčem k poznání evoluce. Vědci popsali DNA chromozomu Y
- Jak se mozek zotavuje po mrtvici? Odpovědi přináší studie českých vědců
Biologie a lékařské vědy
Vědecká pracoviště
- Biofyzikální ústav AV ČR
Biotechnologický ústav AV ČR
Fyziologický ústav AV ČR
Mikrobiologický ústav AV ČR
Ústav experimentální botaniky AV ČR
Ústav experimentální medicíny AV ČR
Ústav molekulární genetiky AV ČR
Ústav živočišné fyziologie a genetiky AV ČR
Cílem výzkumu je poznávání procesů v živých organismech, a to na úrovni molekul, buněk i organismů. Biofyzikální výzkum se zabývá studiem vztahu DNA – protein a vlivu faktorů životního prostředí na organismy. V oblasti molekulární genetiky a buněčné biologie jsou studovány zejména signální cesty pro spouštění reakcí a odezvy cílových genů na tyto signály; zvláštní pozornost je věnována studiu buněčných mechanismů imunitních odpovědí. Sledovány jsou rovněž genomy mikroorganismů a procesy směřující k moderním technologiím přípravy látek s definovanými biologickými účinky. V oblasti fyziologie a patofyziologie savců a člověka je výzkum zaměřen na kardiovaskulární fyziologii, neurovědy, fyziologii reprodukce a embryologii s cílem vytvořit teoretické základy preventivní medicíny. V oblasti experimentální botaniky se výzkum věnuje genetice, fyziologii a patofyziologii rostlin a moderní rostlinné biotechnologii. Sekce zahrnuje 8 vědeckých ústavů s přibližně 1930 zaměstnanci, z nichž je asi 690 vědeckých pracovníků s vysokoškolským vzděláním.